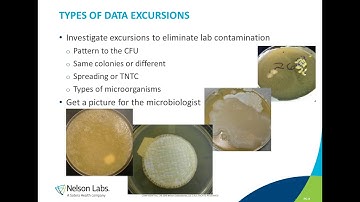
Microbiological Control in a Pharmaceutical Manufacturing Environment

⬇ DOWNLOAD NOW
Kalau muncul iklan pop-up, tutup lalu klik tombol kembali
Download lagu Validation of Microbiological Control Measures secara gratis hanya untuk keperluan promosi. Dukung artis favorit kamu dengan membeli musik original di iTunes atau platform resmi lainnya.
![Validation/Verification of Multi-target Tests in Microbiology [Hot Topic]](https://i.ytimg.com/vi/aYxPd71LGqY/hqdefault.jpg?sqp=-oaymwE9COADEI4CSFryq4qpAy8IARUAAAAAGAElAADIQj0AgKJDeAHwAQH4Af4EgALgA4oCDAgAEAEYZSBlKGUwDw==&rs=AOn4CLA3ytAvsVCqYvCAhMaNZRZjjDyoIA) Validation/Verification of Multi-target Tests in Microbiology [Hot Topic]
Validation/Verification of Multi-target Tests in Microbiology [Hot Topic]
 Practical aspects of microbiological method validation and verification - Roy Betts (2022)
Practical aspects of microbiological method validation and verification - Roy Betts (2022)
 ICMSF 2017 03 "Microbiological Testing for Validation and Verification", Katherine M.J. Swanson
ICMSF 2017 03 "Microbiological Testing for Validation and Verification", Katherine M.J. Swanson
Microbiological Control in a Pharmaceutical Manufacturing Environment
Microbiological Control in a Pharmaceutical Manufacturing Environment
 Preservative Efficacy Test | European Pharmacopoeia | Pharmaceutical Microbiology
Preservative Efficacy Test | European Pharmacopoeia | Pharmaceutical Microbiology
 ID Laboratory Videos: Antibiotic susceptibility testing
ID Laboratory Videos: Antibiotic susceptibility testing
 What is Method Validation? How to perform Method Validation?
What is Method Validation? How to perform Method Validation?
 Microbiological Quality Control of Liquid Samples in Pharma-Compliant Industry
Microbiological Quality Control of Liquid Samples in Pharma-Compliant Industry